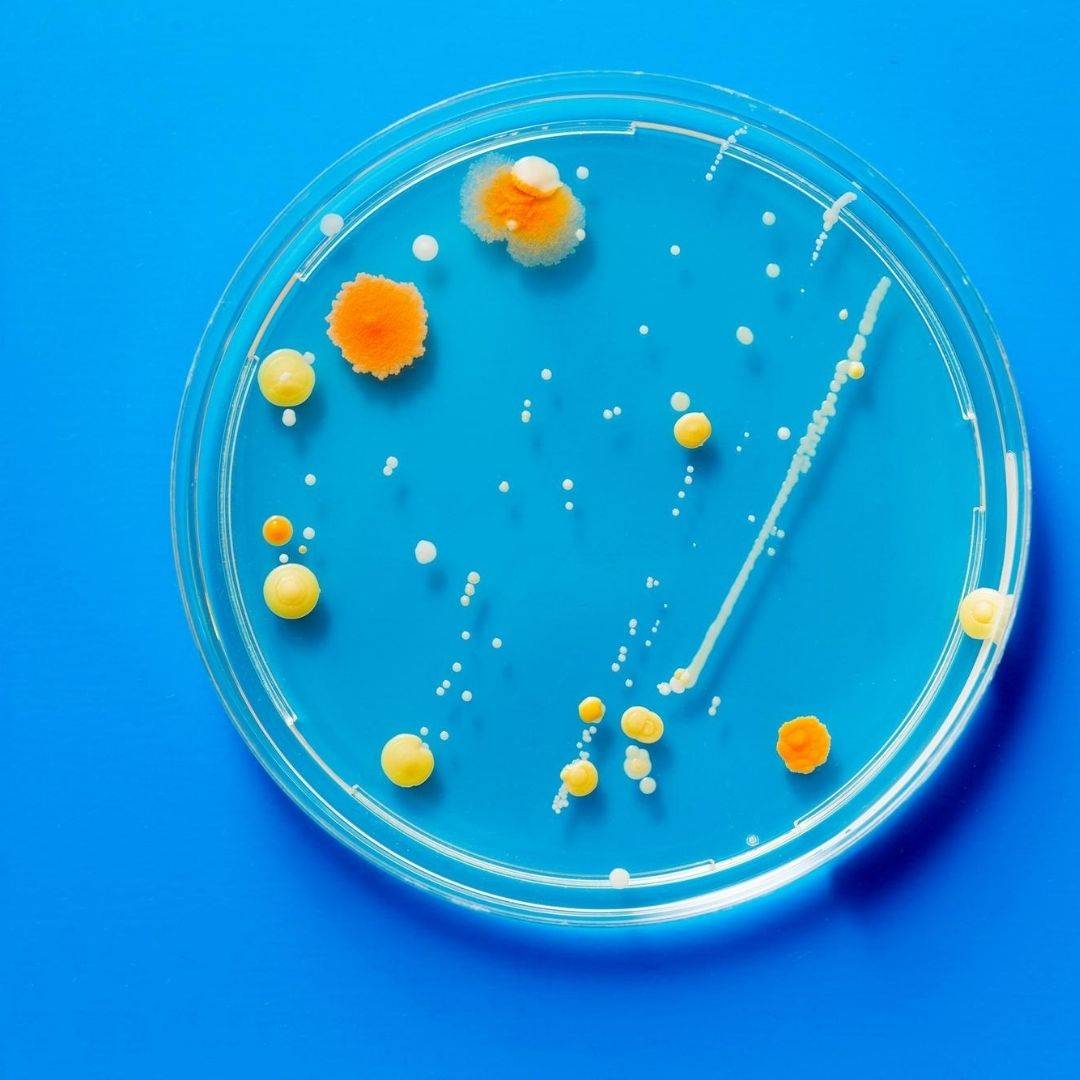
lab copper

The need for face masks remains important. It has been proven that face masks play a huge role in mitigating the spread of the virus. They are a part of our new ‘normal life’.
Lately, face masks made with copper have grown in popularity due to their antimicrobial properties. Many health experts recommend the use of this natural mineral – known as a born virus killer - as it is believed to be the best available material for virus protection. How much protection does a copper face masks really offer against coronavirus?
What is so special about copper?
The natural germ-killing properties of copper are well-established. Copper has shown throughout history to be very effective thanks to its antiviral and antibacterial possessions. In Ancient times - long before microbes were known to play a role in diseases - the Egyptians used the metal in medicinal preparations to sterilise wounds.

Decades of research has shown that copper has been proven to kill pathogens, including bacteria, viruses and other micro-organisms that cause diseases. Since 2008, copper has been recognised as a ‘antimicrobial agent, due to its potent ability to kill pathogens and slow down their transmission.
How effective is a copper filter mask?
A copper filter mask will not only act as a barrier between you and your environment - protecting the person wearing it - but the copper nanoparticles will also shield other people as the copper filter kills microbes.
The copper filter mask has also indicated to provide a higher level of protection than that of surgical masks. On top of the antiviral protection naturally provided by the copper material, they have been shown to help limit the spread of salmonella, e.coli and influenza. They have been proven to filter more than 99.9% of harmful particles.
Unlike glass or stainless steel, copper has self-disinfecting properties. A study of the Journal of Medicine has shown that the survival rate of bacteria and viruses on copper is significantly less than on plastic or stainless steel. When a virus lands on a copper surface, the copper ions attack and kill the cells instantly.
What kinds of microbes can copper kill?
Medical studies have revealed that copper can kill a range of viruses, including Influenza (H1N1 / H9N2) in under 20 minutes. Another copper experiment with Michael Mosley showed that copper achieved a 99.9% reduction and destruction of MRSA – a very infectious bacterium - within 1 minute.
Please note that the copper used in this mask’s filter has not been tested against the COVID-19 strain of coronavirus.
How does copper kill viruses & bacteria?
The graphic below shows in a simple way how copper ions can kill harmful viruses and bacteria.

Copper ions need to interact with a microbe to become reactive. When a microbe comes in contact with copper, the copper ions deactivate the germ as a ‘grenade’.
They puncture through the microbe’s outer layer and affect its genetic material. This will cause it to literally ‘explode’, killing the cell.
Enveloped viruses like the coronavirus are more sensitive to copper. Copper alters the structure destroying the envelope protein of the virus, rendering them ineffective.
Studies revealed that the moment the microbial particles come in contact with the copper surface, they start to die. This process is called ‘contact killing’.
How many layers of protection does the Copper Filter Mask provide?
The Bacteria & Asthma Protective Face Mask is made out of three layers. The virus-repellent copper filter has been developed to inactivated bacteria, viruses or harmful pathogens.
The layers provide the mask with remarkable filtration efficiency, while the copper filter has been shown to inactivate bacteria, harmful pathogens and viruses, including the bovine coronavirus, with 99.99% efficiency.
Can I wash the copper filter face mask?
The great advantage of our Bacteria & Asthma Protective Face Mask by Dr. Hoffmann is that the device is sustainable, eco-friendly and cost-effective. The filter in the mask can be worn consecutively for up to 2 weeks. After that time, the filters can be washed under running water without hurting their filtration efficacy. The mask should be washed in distilled or cooled boiled water. You can use some soft washing liquid or detergent.

For the mask, we recommend washing every 3-5 days:
- Firstly, take out the filter
- Place the mask in a bowl ensuring that the elastic ear loops are kept outside the bowl
- Add cooled boiled water (or distilled water) and leave it to rest for 15 minutes. This process ensures hygiene. If you want, use some mild detergent.
- GENTLY massage
- Squeeze out excess water and lay the face mask flat to dry naturally
For the filter, we recommend cleaning every 2 weeks
- Hold the filter under running water
- Do not use detergent or washing filter
- Gently massage
- Leave the filter to dry naturally. Do not use the microwave!
Should I buy a copper filter face mask?
All signs we can find, point to the fact that the natural mineral copper is a promising new asset in the world of virus protection.
The Bacteria & Asthma protective Face Mask incorporates a patented Ding-Filter that uses copper filter technology. Our face mask has been manufactured in Germany to very high standards. The filter is made of a very fine copper mesh, improving performance significantly. Thanks to its large surface, the potentially harmful particles are neutralised before entering your lungs. This face mask offers the ultimate protection against the Covid-19 risks and is very comfortable to wear.

In addition to the copper’s antimicrobial benefits, the masks are also sustainable, reusable and washable. You can use the mask over and over again, while the filters can be washed and replaced. Replacement filter sets are available with 4 filters.
The Bacteria & Asthma Facemask are the perfect choice for in public transport, shops, at work or around vulnerable individuals.
There is also a special copper filter face mask for children available.
Conclusion
The antimicrobial properties of copper have received much attention recently, and rightfully so. Studies have recognised the potential of copper as the mineral attacks bacteria and virus cells and destroys the harmful pathogens.
The technology has become a viable strategy against the spread of the coronavirus as infections continue to rise. Copper is now even used in face masks to give you optimal protection. The Copper filter mask has used the microbe-resistant material in the filter to defend you against viral growth and contamination. Our comfortable Bacteria & Asthma Protective Face Mask by Dr. Hoffmann will ensure you are protected against the transmission of Covid-19.
About Bettercaremarket
Bettercaremarket is your leading supplier of healthcare essentials and your #1 destination for quality incontinence supplies, mobility equipment, independent living aids for seniors, disability aids, rehab and therapy products and medical supplies.
We help NDIS-participants, aged care facilities, home care package providers, occupational therapists and allied health providers find the best solutions to solve their need.



